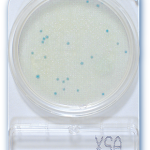

Compact Dry ETB(Enterobacteriacae)
Price range: $88.18 through $2,520.79
Compact Dry ETB(Enterobacteriacae)
Manufacturer : NISSUI Pharmaceutical Co., Ltd.
Cat No : 1002941 | 1002942 | 1402942 | 1502889
- Description
- Size Guide
- Additional information
- Specification
- Datasheet
- Vendor Info
- More Products
Description
Compact Dry ETB(Enterobacteriacae)

Enterobacteriaceae is a family under the Gram-negative bacteria with known characteristic of being facultative anaerobe, non-spore former, and commonly motile but non-motile genera are also present.
Enterobacteriaceae is commonly found in the environment as well as the gut of animals. Almost all foodborne pathogenic bacteria fall under this family including Citrobacter, Enterobacter, Escherichia, Klebsiella, Proteus, Salmonella, Serratia, Shigella and Yersinia. Enterobacteriaceae is release parameter in various food, beverages, pharmaceutical, nutraceutical, and cosmetic samples.
As a recent development in food safety, Enterobacter sakazakii is being monitored in formula milk due to high risk of milk contamination, as well as its health impact when ingested by babies.
Using Compact Dry ETB it´s very easy to detect Enterobacteriacae. It´s substrates allows the easy differentiation of the Enterobacteriacae from other groups.

Incubation time
24 – 48 hours
Incubation temperature
35 – 37° C
Please use the incubation temperature/time according to the legal specification of each country’s food analysis regulations.
Result Interpretation
Red or purple colonies and otherwise colored colonies

Additional information
| PACKAGING TYPE | 40 Plates, 240 Plates, 500 Plates, 1404 Plates |
|---|
Specification
Features and Benefits include:
- Ready to use
- No spreading
- Long shelf life at room temperature
- Easily stackable in incubator
- Easy identification of presumptive colonies on chromogenic media
- Wide choice of plates available including Total Counts, E. coli, Listeria sp., Salmonella sp., Vibrio parahaemolyticus, Enterococcus, Enterobacteriaceae, Yeast and Molds.
Membrane filter method: procedure for CompactDry™

Additionally membrane filters can be tested using CompactDry™ plates. Filter 1ml water or any other liquid using an ordinary membrane filter (e.g. 47 mm, 45 µm), then pipette 1 ml of sterile water into the middle of the Compact Dry plate and place the filter on the CompactDry™ plate. The filter should be trap side up. Colonies will grow on the filter.
How-to-use-Membrane-Filter-method-on-Compact-Dry-Plates-1
PRODUCT:
| Package Size | Quantity | |||
|---|---|---|---|---|
| 40 plates | 40 Plates/Box | |||
| 240 plates | 240 Plates/Box | |||
| 500 plates | 500 Plates/Box | |||
| 1404 Plates | 1404 Plates/Box | |||